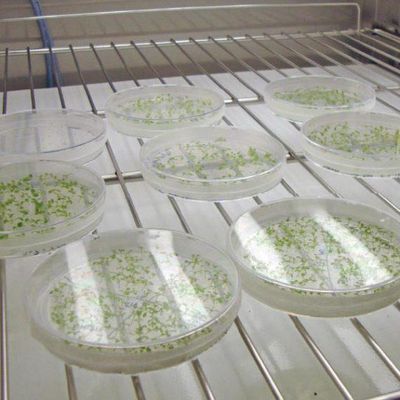

Aralab
- Home
- Companies
- Aralab
- Applications
- Plant Research Chamber for Tissue ...
Plant Research Chamber for Tissue Culture Growth - Agriculture
FromAralab
Tissue Culture Growth cabinets offering unsurpassed accuracy, reliability and reproducibility of Temperature, Humidity and Light conditions.
Stay in the loop!
Select your areas of interest to receive industry updates.
